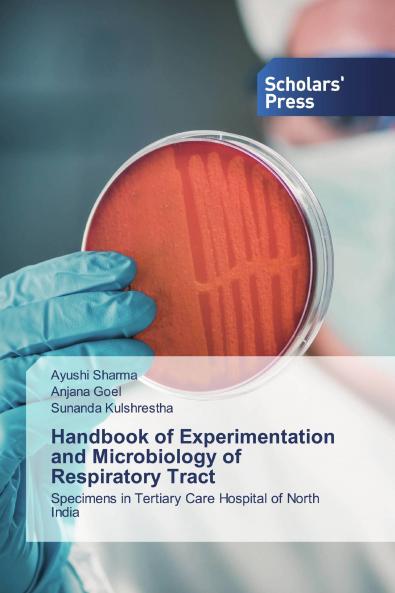
Handbook of Experimentation and Microbiology of Respiratory Tract

English
Paperback
₹4483
(All inclusive*)
Delivery Options
Please enter pincode to check delivery time.
*COD & Shipping Charges may apply on certain items.
Review final details at checkout.
Looking to place a bulk order? SUBMIT DETAILS
About The Book
Description
Author
Respiratory tract infections are the most common kind of infections found in the population. The microbes easily get into the body through the source of air one inhales and cause infection. They are easily procurable in samples like sputum or naso-pharyngeal specimen from the person. The handbook compiles all related experimentation that will be helpful for researchers to devise the working plan to find out the type of microbial infection in the sample collected.
Delivery Options
Please enter pincode to check delivery time.
*COD & Shipping Charges may apply on certain items.
Review final details at checkout.
Details
ISBN 13
9786138925736
Publication Date
-16-03-2020
Pages
-56
Weight
-90 grams
Dimensions
-150x220x3.48 mm